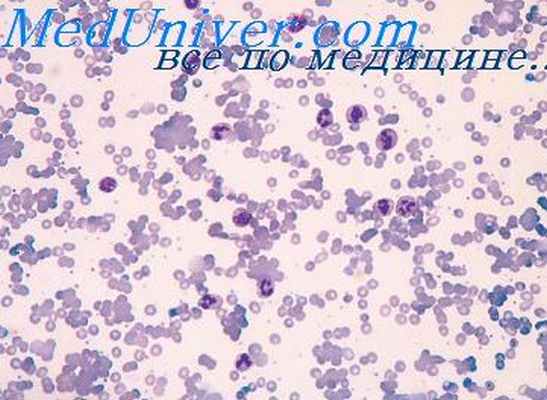
гемоглобинозы

Дефицит пируваткиназы у плода. Гемоглобинозы
Добавил пользователь Alex Обновлено: 29.01.2026
К мембранопатиям относят гемолитические анемии, обусловленные генетическим дефектом белковой (белковозависимые мембранопатии) или липидной (липидозависимые мембранопатии) компоненты цитоплазматической мембраны эритроцитов.
К белковозависимой мембранопатии относится наследственная микросфероцитарная анемия Минковского-Шоффара. В основе заболевания лежит дефект генов, кодирующих мембранные белки цитоскелета эритроцитов.
Эритроциты при болезни Минковского-Шоффара содержат аномальные формы спектрина, анкирина и белков, принимающих участие в поддержании нормальной двояковогнутой формы эритроцитов. В результате эритроциты лишаются возможности удерживать свою обычную форму, приобретают сферическую форму, теряют пластичность, способность к деформации, что нарушает их прохождение через узкие капилляры и особенно через синусы селезенки. Эритроциты в них задерживаются, что способствует их частичному разрушению макрофагами. Они теряют часть своей поверхности, уменьшаются в размере и превращаются в микросфероциты. Кроме того, дефектная мембрана эритроцитов становится высокопроницаемой для ионов натрия и воды, удаление избытка которых требует больших энергетических затрат, что приводит к сокращению срока их жизни со 120 до 12—14 дней.
Основными симптомами заболевания являются бледность, желтуха, спленомегалия, которые проявляются обычно с детства. Заболевание протекает с периодами ремиссии и обострения вплоть до гемолитического криза. Развитие обострения болезни связано с действием провоцирующих факторов, таких как психические переживания, физические нагрузки, инфекции. Выраженность анемии и клинических проявлений зависит от периода заболевания.
Дефекты белков мембраны эритроцитов могут приводить и к другим формам гемолитической анемии — наследственному эллипто- цитозу, стоматоцитозу и др. Это редко встречающиеся варианты гемолитической анемии.
Другой вид мембранопатии обусловлен появлением аномальных липидов в составе мембраны эритроцитов. Это приводит к своеобразным морфологическим изменениям в эритроцитах. В таких эритроцитах появляются выпячивания мембраны различного размера, расположенные на разных расстояниях друг от друга по поверхности клетки, в результате клетки становятся похожими на листья травянистого растения аканта, поэтому их называют акантоцитами. Они имеют и другое название — шпоровидные клетки. Низкая деформируемость, пониженная резистентность таких эритроцитов к различным воздействиям (изменению осмотического давления, температурным колебаниям, механическим факторам) являются причиной их повышенного распада и развития анемии.
Подобные изменения эритроцитов встречаются, в частности, у пациентов с наследственной абеталипопротеинемией.
Необходимо заметить, что эритроциты такой формы не являются строго специфичными для наследственного акантоцитоза. Они могут встречаться также при циррозе печени, в связи с нарушением липопротеинового обмена, при авитаминозе Е, у лиц с удаленной селезенкой.
Ферментопатии
В настоящее время известно более 20 наследственных энзимопа- тий эритроцитов, которые приводят к снижению продолжительности их жизни и повышенному гемолизу. К ним относятся нарушения активности ферментов гликолиза, пентозофосфатного цикла, системы глютатиона, метаболизма адениннуклеотидов и др. Из всех ферментопатий чаще всего встречаются гемолитические анемии, связанные с дефицитом ферментов пируваткиназы и особенно Г-6- ФДГ. Считается, что приблизительно 1/20 человечества имеет дефект фермента Г-6-ФДГ. Дефицит Г-6-ФДГ особенно отмечается в районах распространения малярии.
Гемолитическая анемия, обусловленная недостаточностью Г-6-ФДГ.
Известно большое количество мутантных форм Г-6-ФДГ (по данным разных авторов от 90 до 250), из которых две являются основными: более легкая африканская форма — тип А и более тяжелая средиземноморская форма — тип В. Последняя характеризуется не только снижением активности Г-6-ФДГ, как это имеет место при африканской форме, но и уменьшением его количества в эритроцитах.
Наследование дефицита Г-6-ФДГ сцеплено с Х-хромосомой, поэтому среди заболевших лиц преобладают мужчины.
При недостаточной активности Г-6-ФДГ нарушается пентозо- фосфатный цикл в эритроцитах, в связи с чем в недостаточном количестве синтезируется восстановленный кофермент НАДФН и не происходит образования восстановленного глютатиона. Восстановленный глютатион — необходимый компонент антиоксидантной системы эритроцитов. Он осуществляет защиту тиоловых групп гемоглобина и мембрану эритроцитов, прежде всего их липидов, от активных форм кислорода, образующихся в процессе жизнедеятельности самого эритроцита, а также от различного рода окислителей, возникающих при инфекциях, приеме определенных лекарственных препаратов, являющихся сильными окислителями (антималярий- ных, противотуберкулезных, сульфаниламидов, нитрофуранов, анальгетиков и пр.), при употреблении в пищу бобов vicia vafa. Эритроциты с пониженным содержанием глютатиона легко подвергаются действию окисляющих веществ. Образующиеся активные формы кислорода вызывают образование гидроперекисей ненасыщенных жирных кислот фосфолипидов, входящих в состав клеточных мембран, их разрушение и повышение проницаемости мембран эритроцитов для натрия и воды, что способствует их гемолизу. В результате действия гидроперекисей происходят также преципитация гемоглобина и отложение его в эритроцитах в виде телец Гейнца (округлых преципитатов числом более четырех). Это вызывает нарушение пластичности эритроцитов и снижение их способности к деформации при прохождении через капилляры.
Заболевание, связанное с дефицитом ферментов Г-6-ФДГ, характеризуется желтушностью кожных покровов, умеренной нормохром- ной анемией, выраженность которых нарастает при переутомлении, инфекционных заболеваниях. Эти явления отмечаются с детских лет. Прием определенных лекарств-окислителей может привести к резкому обострению анемии. Гемолиз наступает не сразу после приема препарата, а спустя 2—3 дня. Возникает желтушное окрашивание кожи и слизистых оболочек, за счет гемоглобинурии моча приобретает темный цвет. Развивается тяжелая анемия, сопровождающаяся резким падением количества эритроцитов, снижением содержания гемоглобина (40—60 г/л), ретикулоцитозом, появлением в эритроцитах телец Гейнца. Форма эритроцитов самая разнообразная — от единичных микросфероцитов до мишеневидных макроцитов.
Гемолитическая анемия с дефектом пируваткиназы. Основным источником энергии в эритроцитах является гликолиз, поэтому снижение активности гликолитического фермента пируваткиназы тормозит производство энергии и снижает выработку АТФ. Дефицит энергии приводит к нарушению работы мембранных насосов, изменению ионного состава эритроцитов, укорочению продолжительности их жизни. Разрушение эритроцитов осуществляется главным образом внутриклеточно макрофагами селезенки и печени.
Дефицит пируваткиназы обнаруживается практически только у детей, у которых выраженный гемолиз имеется с самого рождения.
Гемоглобинопатии (гемоглобинозы)
Это состояние, вызванное мутацией генов, контролирующих синтез цепей глобина. Обычно эта патология встречается в странах с жарким климатом, эндемичных по малярии (в странах Африки, Средиземноморья, в Индии, Пакистане), реже в Средней Азии, на Кавказе.
В настоящее время описано более 200 аномальных типов гемоглобина, ведущих к гемоглобинопатиям. Правда, не все аномальные гемоглобины приводят к появлению патологических явлений. Некоторые же приводят к патологии, степень которой может быть различной — от небольших клинических проявлений, возникающих только при определенных условиях, до тяжелых, смертельных форм при гомозиготном наследовании мутантного гена.
Различают две группы наследственных гемоглобинопатий. Одна группа обусловлена наследственным дефектом первичной структуры цепей глобина, когда одна аминокислота в белковой цепи гемоглобина замещается другой. Вторая группа обусловлена наследственным дефектом синтеза некоторых полипептидных цепей глобина и заменой их другими.
Наследственные гемоглобинопатии относятся к числу наиболее распространенных в человеческой популяции генетических аномалий. Среди известных форм гемоглобинопатий наибольшее значение в клинической практике имеют серповидноклеточная анемия (ге- моглобиноз S) и талассемии.
Серповидноклеточная анемия (гемоглобиноз S). Нормальный гемоглобин взрослого человека состоит из НЬА (96%), НЬА2 (2,5%) и HbF (1,5%). Серповидноклеточная анемия — вид гемоглобинопатии, при котором появляется аномальная форма гемоглобина — HbS (от англ, sikle — серп). Эта форма гемоглобинопатии получила такое название, поскольку гемоглобин при определенных условиях вызывает деформацию эритроцита и придает ему серповидную форму. Гемоглобин S образуется в результате точечной мутации в структурном гене, приводящей к замещению глутаминовой кислоты, стоящей в шестом положении p-цепи, валином. Такая замена уменьшает растворимость гемоглобина. Отличительными особенностями HbS являются следующие: растворимость его восстановленной формы примерно в 100 раз ниже нормального НЬА, он приобретает способность к полимеризации и выпадению в осадок в виде кристаллов. Эритроциты с высокой концентрацией HbS при падении парциального давления кислорода в окружающей среде, при циркуляции в зоне гипоксии, ацидоза деформируются, приобретают форму серпа, повреждаются выпавшими острыми кристаллами.
Наследование аномального гена может быть гетерозиготным и гомозиготным. При гетерозиготном наследовании патологический гемоглобин S составляет обычно 20—45% всего гемоглобина клетки, а остальное количество приходится на нормальный гемоглобин А, поэтому у людей с такими нарушениями обычно развивается легкая форма заболевания, у 8—10% даже клинически не проявляющаяся. В случаях гомозиготного наследования в эритроцитах содержится 80—100% гемоглобина S, поэтому тяжелая анемия возникает у гомозиготных по HbS детей.
Изменение формы эритроцитов снижает их деформируемость, что затрудняет прохождение эритроцитов по микрососудам и способствует замедлению кровотока, развитию стаза в сосудах микро- циркуляторного русла. В результате возникает ишемическое повреждение различных тканей. Ишемическому повреждению тканей способствует закупорка сосудов продуктами гемолиза измененных эритроцитов. Средняя продолжительность жизни эритроцитов у больных, гомозиготных по HbS, составляет в среднем 17 сут.
В большинстве неосложненных случаев анемия при гемоглоби- нозе S умеренная (содержание гемоглобина — 100—80 г/л, эритроцитов — 3,5—3,0 • 10 12 /л), носит нормохромный характер. В мазке наряду с серповидными эритроцитами (или дрепаноцитами) выявляются мишеневидные эритроциты с базофильной пунктацией цитоплазмы (рис. 15.6) Содержание ретикулоцитов повышено. Отмечаются нейтрофил ьный лейкоцитоз, тромбоцитоз.
Помимо серповидноклеточной анемии известны формы гемоглобинопатий, характеризующиеся наличием других аномальных типов гемоглобина. Из этих аномалий чаще всего встречается гемоглобинопатия С. В гемоглобине С глутаминовая кислота в шестом положении (3-цепи замещена лизином, вследствие чего гемоглобин кристаллизуется, но при этом эритроциты приобретают не серповидную, а мишеневидную форму. Клинические проявления выявляются только при гомозиготном носительстве.

Рис. 15.6. Картина периферической крови при серповидноклеточной анемии (по Lippincott Williams-Wilkins, 2010)
Возможно полное или частичное угнетение синтеза любой цепи глобина, но чаще всего встречается патология а- и особенно (3-цепи, в связи с чем различают два основных типа талассемий: альфа и бета.
Альфа-талассемия. Спектр клинических проявлений заболевания весьма широк: от бессимптомного носительства мутантного гена до патологии, не совместимой с жизнью. В синтезе a-цепи глобина принимают участие четыре гена. Клиническая картина а-талассемии зависит от количества дефектных генов, ответственных за синтез a-цепи, и степени нарушения синтеза последней. Адекватное количество a-цепей способно образовываться до тех пор, пока не поражаются три или четыр а-глобиновых гена. В случаях полного угнетения синтеза a-цепи не образуются гемоглобины А, А2 и F. Избыточные у-цепи глобина принимают участие в формировании патологического гемоглобина Барта с очень высоким сродством к кислороду. Этот гемоглобин не отдает кислород в ткани плода, из-за чего возникают тканевая гипоксия и, как правило, внутриутробная смерть.
При мутации трех а-глобиновых генов образуется гемоглобин Н, состоящий из четырех (3-цепей, подобно гемоглобину Барта имеющий слишком высокое сродство к кислороду и легко выпадающий в осадок. Эритроциты, содержащие гемоглобин Н, характеризуются меньшей продолжительностью жизни и быстро разрушаются в селезенке. Это ведет к развитию умеренной микроциртарной анемии вследствие гемолиза эритроцитов.
Дисфункция одного или двух из четырех а-глобиновых генов либо клинически бессимптомна, либо вызывает незначительную микроцитарную гемолитическую анемию.
Бета-талассемия. Патологические изменения при (3-талассемии обусловлены нарушением синтеза (3-цепи глобина и образованием нестабильных гемоглобинов, содержащих только а-цепи.
По тяжести клинической картины (3-талассемии делят на большую, малую и минимальную. Большая талассемия (болезнь Кули) встречается у гомозиготов и характеризуется резким снижением синтеза НЪА при значительном компенсаторном увеличении синтеза HbF и НЬА2 — форм гемоглобинов с более высокой кислородосвязывающей способностью по сравнению с НЬА. Неэффективный эритропоэз из-за избыточного синтеза a-цепи, снижение кислородной емкости крови ведут к развитию тканевой гипоксии, интенсивной эритроидной гиперплазии и значительному расширению объема зон кроветворения, в том числе на все черепные кости. Гиперплазия костно-мозгового кроветворения в костях верхней челюсти приводит к типичному изменению лица: скулы выдаются, прикус зубов нарушается из-за того, что верхняя челюсть становится диспропорционально больше, чем нижняя, поэтому болезнь характеризуется не только прогрессирующей анемией с гепатоспленомегалией, повышенным гемолизом с урибилинурией, но и остеопорозом со своеобразными изменениями лицевого скелета по «монголоидному» типу.
В крови наблюдается тяжелая гипохромная, микроцитарная анемия, сопровождающаяся нормальным или повышенным содержанием железа сыворотки. В мазке резко выражен анизопойкилоцитоз, преобладают мишеневидные эритроциты, часто выявляется базо- фильная пунктация эритроцитов (рис. 15.7). Отмечается высокий периферический ретикулоцитоз. Характерна лейкопения с относительным лимфоцитозом и только в период криза возможен нейтро- фильный лейкоцитоз. Количество тромбоцитов нормальное или сниженное.

Рис. 15.7. Картина периферической крови при талассемии (по Lippincott Williams-Wilkins, 2010)
Малая и минимальная р-талассемии возникают в результате наследования дефектного гена лишь от одного из родителей. Болезнь протекает с нерезко выраженными клиническими проявлениями, иногда бессимптомно. Гематологические показатели при гетерозиготной талассемии могут варьировать в значительных пределах. Как правило, наблюдается микроцитарная гипохромная анемия. При исследовании мазка периферической крови можно обнаружить выраженный пойкилоцитоз — мишеневидные эритроциты, дакриоци- ты (каплеподобные клетки), эритроциты с базофильной зернистостью, ядерные эритроциты.
Дефицит пируваткиназы у плода. Гемоглобинозы
Дефицит пируваткиназы у плода. Гемоглобинозы
Дефицит пируваткиназы встречается в Советском Союзе, в том числе у новорожденных, в виде тяжелой желтушной формы гемолитической болезни новорожденных. Кризы возникают спонтанно или провоцируются инфекциями. В крови могут появиться эритроциты сферической, мишеневидной формы, напоминающие малину. Патоморфологически отмечаются умеренное увеличение селезенки и печени, гиперплазия эритроцитарного ростка костного мозга и другие неспецифические проявления внутрисосудистого гемолиза.
Дефицит других ферментов гликолиза нередко выражается в сочетании гемолитической анемии с различными нарушениями развития. Так, дефицит глицероальдегидфосфатдегидрогеназы (ГАФД) сочетается с ихтиозом. Дефицит фосфофруктокиназы может сочетаться с миопатией, дефицит гексокиназы — с гликогенозом. Описаны случаи желтухи новорожденных при сочетанном дефиците гексокиназы и 6-фосфоглюконатдегидрогеназы (6-ФГД), а также при дефиците 2,3-д ифосфоглицеромутазы (2,3-ДФМ), триозофосфатизомеразы, глюкозофосфатизомеразы.
Дефицит ферментов обмена глютатиона сопровождается изменениями, напоминающими фентопатию Г-6-ФДГ. Это обусловлено участием этих ферментов в пентозофосфатном цикле. Случаи гемолитических состояний у новорожденных с картиной ГБН описаны при дефиците глютатионредуктазы, глютатионсинтетазы, глютатионпероксидазы. Дефицит аденозинтрифосфатазы (АТФ-аза) и аденилаткиназы также может привести к гемолитической желтухе новорожденных.
Причиной транзиторной доброкачественной гипербилирубинемии и желтухи новорожденных может быть временная недостаточность фосфоглицероизомеразы, глицеральдегид-3-фосфатдегидрогеназы и 2,3-дифосфоглицерата.
Гемолитические заболевания, связанные с патологией гемоглобина. Относящиеся к данной группе гемоглобинозы и талассемии являются одними из самых распространенлых наследственных заболеваний человечества. В Средиземноморье, Африке, Юго-Восточной Азии носителями патологических генов являются до 40% населения. В Советском Союзе гемоглобинозы и талассемии встречаются в Закавказье и Средней Азии, спорадические случаи аномальных гемоглобинозов описаны в Европейской части СССР.
Нередки сочетания различных видов патологии гемоглобина у одного больного.
Гемоглобинозы
Гемоглобинозы — наследственные заболевания, связанные с нарушением синтеза глобина — заменой аминокислот в его цепях. В результате образуются патологические, аномальные гемоглобииы — HbS, HbC, HbD. Другие аномальные гемоглобины (в настоящее время их известно свыше 200) описаны лишь в отдельных семьях. Они именуются по названию города, местности где были выявлены (Hb Zurich, Hb Москва и др.), или фамилии больного. Наследуются гемоглобинозы аутосомно-доминантно.
В течение индивидуального развития состав гемоглобина меняется. У эмбрионов до 12 нед имеется Hb Grower. Затем он заменяется на фетальный гемоглобин (HbF). Незадолго перед рождением в крови плода появляется НbА (взрослый). В крови новорожденного содержится 60—80% HbF, замена на НbА происходит в течение первого года жизни. В крови взрослого в основном содержится HbА, а также 2—3.% гемоглобина А2(НbА2) и 1—2% HbF.
При гемоглобинозах замена аминокислот в молекуле гемоглобина, особенно в области контактов глобина с гемом, ведет к неустойчивости, нестабильности ее и к развитию гемолиза. Кроме этого в ряде случаев замена аминокислот обусловливает прочную связь аномального гемоглобина с кислородом — метгемоглобинемию. В результате после рождения развивается хроническая гипоксия с ацидозом.
Информация на сайте подлежит консультации лечащим врачом и не заменяет очной консультации с ним.
См. подробнее в пользовательском соглашении.
Дефицит пируваткиназы: эпидемиология, молекулярно-генетическая характеристика и современные подходы к диагностике (обзор литературы)
Наследственная несфероцитарная гемолитическая анемия вследствие дефицита пируваткиназы – наиболее распространенная среди всех ферментопатий эритроцитов. Фермент пируваткиназа необходим для последней ключевой стадии гликолиза – образования енольной формы пирувата и аденозинтрифосфата (АТФ) (50 % всей энергии АТФ эритроцитов). Недостаточное количество АТФ напрямую влияет на продолжительность жизни эритроцитов – сокращая ее. Поврежденные эритроциты раз- рушаются в капиллярах селезенки, приводя к развитию хронической гемолитической анемии. Дефицит пируваткиназы является аутосомно-рецессивным заболеванием в результате гомозиготных и компаунд-гетерозиготных мутаций в гене PKLR. Точные дан- ные о частоте встречаемости дефицита пируваткиназы отсутствуют, однако оцениваемая частота варьирует от 3:1 000 000 до 1:20 000. Клинические проявления заболевания варьируют по степени тяжести, которая может меняться с возрастом. Диагностика дефицита пируваткиназы основана на определении активности пируваткиназы и молекулярно-генетическом исследовании гена PKLR. Многообразие клинических проявлений, возможных осложнений, а также малодоступность диагностических методов затрудняют постановку диагноза.
Ключевые слова
Об авторах
Россия, 117997, Москва, ул. Островитянова, 1
Екатерина Александровна Черняк, врач-гематолог консультативного отделения, научный сотрудник отдела оптимизации лечения гематологических заболеваний Института гематологии, иммунологии и клеточных технологий
Россия, 117997, Москва, ул. Саморы Машела, 1
Список литературы
1. Quintana-Bustamante O., Fañanas-Baquero S., Orman I., Torres R., Duchateau P., Poirot L., Gouble A., Bueren J.A., Segovia J.C. Gene editing of PKLR gene in human hematopoietic progenitors through 5' and 3' UTR modifi ed TALEN mRNA. PLoS One 2019;14(10):e0223775. doi: 10.1371/journal.pone.0223775.
2. Bianchi P., Fermo E., Glader B., Kanno H., Agarwal A., Barcellini W., Eber S., Hoyer J.D., Kuter D.J., Maia T.M., Mañu-Pereira M.D.M., Kalfa T.A., Pissard S., Segovia J.C., van Beers E., Gallagher P.G., Rees D.C., van Wijk R.; with the endorsement of EuroBloodNet, the European Reference Network in Rare Hematological Diseases. Addressing the diagnostic gaps in pyruvate kinase deficiency: Consensus recommendations on the diagnosis of pyruvate kinase deficiency. Am J Hematol 2019;94(1):149–61. doi: 10.1002/ajh.25325.
3. Grace R.F., Cohen J., Egan S., Wells T., Witherspoon B., Ryan A., Salek S.S., Bodie S., Klaassen R.J. The burden of disease in pyruvate kinase deficiency: Patients’ perception of the impact on health-related quality of life. Eur J Haematol 2018;101(6):758–65. doi: 10.1111/ejh.13128.
6. Chartier M.E., Hart L., Paganelli M., Ahmed N., Bilodeau M., Alvarez F. Successful Liver Transplants for Liver Failure Associated With Pyruvate Kinase Deficiency. Pediatrics 2018;141(Suppl 5):S385–9. doi: 10.1542/peds.2016-3896.
7. He Y., Luo J., Lei Y., Jia S., Liao N. A novel PKLR gene mutation identified using advanced molecular techniques. Pediatr Transplant 2018;22(2). doi: 10.1111/petr.13143.
8. Grace R.F., Mark Layton D., Barcellini W. How we manage patients with pyruvate kinase deficiency. Br J Haematol 2019;184(5):721–34. doi: 10.1111/bjh.15758.
9. van Beers E.J., van Straaten S., Morton D.H., Barcellini W., Eber S.W., Glader B., Yaish H.M., Chonat S., Kwiatkowski J.L., Rothman J.A., Sharma M., Neufeld E.J., Sheth S., Despotovic J.M., Kollmar N., Pospíšilová D., Knoll C.M., Kuo K., Pastore Y.D., Thompson A.A., Newburger P.E., Ravindranath Y., Wang W.C., Wlodarski M.W., Wang H., Holzhauer S., Breakey V.R., Verhovsek M., Kunz J., McNaull M.A., Rose M.J., Bradeen H.A., Addonizio K., Li A., Al-Sayegh H., London W.B., Grace R.F. Prevalence and management of iron overload in pyruvate kinase deficiency: report from the Pyruvate Kinase Deficiency Natural History Study. Haematologica 2019;104(2):e51–3. doi: 10.3324/haematol.2018.196295.
10. Grace R.F., Glader B. Red Blood Cell Enzyme Disorders. Pediatr Clin North Am 2018;65(3):579–95. doi: 10.1016/j.pcl.2018.02.005.
12. Canu G., De Bonis M., Minucci A., Capoluongo E. Red blood cell PK deficiency: An update of PK-LR gene mutation database. Blood Cells Mol Dis 2016;57:100–9. doi: 10.1016/j.bcmd.2015.12.009.
13. Mañú-Pereira M.M., Gonzalez-Roca E., van Solinge W.W., Llaudet- Planas E., Sevilla J., Montllor L., Mensa-Vilaro A., Ploos van Amstel H.K., van Wijk R., Vives-Corrons J. Pyruvate kinase deficiency and severe congenital hemolytic anemia in a double heterozygous patient with paternal transmission of an early germ-line de novo mutation. Am J Hematol 2015;90(12):e217–9. doi: 10.1002/ajh.24178.
14. van Zwieten R., van Oirschot B.A., Veldthuis M., Dobbe J.G., Streekstra G.J., van Solinge W.W., Schutgens R.E., van Wijk R. Partial pyruvate kinase deficiency aggravates the phenotypic expression of band 3 deficiency in a family with hereditary spherocytosis. Am J Hematol 2015;90(3):e35–9. doi: 10.1002/ajh.23899.
15. Grace R.F., Zanella A., Neufeld E.J., Morton D.H., Eber S., Yaish H., Glader B. Erythrocyte pyruvate kinase deficiency: 2015 status report. Am J Hematol 2015;90(9):825–30. doi: 10.1002/ajh.24088.
17. Garate Z., Quintana-Bustamante O., Crane A.M., Olivier E., Poirot L., Galetto R., Kosinski P., Hill C., Kung C., Agirre X., Orman I., Cerrato L., Alberquilla O., Rodriguez-Fornes F., Fusaki N., Garcia- Sanchez F., Maia T.M., Ribeiro M.L., Sevilla J., Prosper F., Jin S., Mountford J., Guenechea G., Gouble A., Bueren J.A., Davis B.R., Segovia J.C. Generation of a High Number of Healthy Erythroid Cells from Gene-Edited Pyruvate Kinase Deficiency Patient-Specific Induced Pluripotent Stem Cells. Stem Cell Reports 2015;5(6):1053–66. doi: 10.1016/j.stemcr.2015.10.002.
18. Jaouani M., Manco L., Kalai M., Chaouch L., Douzi K., Silva A., Macedo S., Darragi I., Boudriga I., Chaouachi D., Fitouri Z., Van Wijk R., Ribeiro M.L., Abbes S. Molecular basis of pyruvate kinase deficiency among Tunisians: description of new mutations aff ecting coding and noncoding regions in the PKLR gene. Int J Lab Hematol 2017;39(2):223–31. doi: 10.1111/ijlh.12610.
19. Unal S., Gumruk F. Molecular Analyses of Pyruvate Kinase Defi cient Turkish Patients from a Single Center. Pediatr Hematol Oncol 2015;32(5):354–61. doi: 10.3109/08880018.2015.1010671.
20. Aydin Köker S., Oymak Y., Bianchi P., Gözmen S., Karapinar T.H., Fermo E., Vergin R.C. A New Variant of PKLR Gene Associated With Mild Hemolysis may be Responsible for the Misdiagnosis in Pyruvate Kinase Deficiency. J Pediatr Hematol Oncol 2019;41(1):e1–2. doi: 10.1097/MPH.0000000000001254.
22. Miwa S., Nakashima K., Ariyoshi K., Shinohara K., Oda E. Four new pyruvate kinase (PK) variants and a classical PK deficiency. Br J Haematol 1975;29:157–69. doi: 10.1111/j.1365-2141.1975.tb01809.x.
23. Svidnicki M.C.C.M., Santos A., Fernandez J.A.A., Yokoyama A.P.H., Magalhães I.Q., Pinheiro V.R.P., Brandalise S.R., Silveira P.A.A., Costa F.F., Saad S.T.O. Novel mutations associated with pyruvate kinase deficiency in Brazil. Rev Bras Hematol Hemoter 2018;40(1):5–11. doi: 10.1016/j.bjhh.2017.08.007.
24. Christensen R.D., Yaish H.M., Nussenzveig R.H., Agarwal A.M. Siblings with severe pyruvate kinase deficiency and a complex genotype. Am J Med Genet A 2016;170(9):2449–52. doi: 10.1002/ajmg.a.37828.
25. Bagla S., Bhambhani K., Gadgeel M., Buck S., Jin J.P., Ravindranath Y. Compound heterozygosity in PKLR gene for a previously unrecognized intronic polymorphism and a rare missense mutation as a novel cause of severe pyruvate kinase deficiency. Haematologica 2019;104(9):e428–31. doi: 10.3324/haematol.2018.214692.
26. Shefer Averbuch N., Steinberg-Shemer O., Dgany O., Krasnov T., Noy-Lotan S., Yacobovich J., Kuperman A.A., Kattamis A., Ben Barak A., Roth-Jelinek B., Chubar E., Shabad E., Dufort G., Ellis M., Wolach O., Pazgal I., Abu Quider A., Miskin H., Tamary H. Targeted next generation sequencing for the diagnosis of patients with rare congenital anemias. Eur J Haematol 2018;101(3):297–304. doi: 10.1111/ejh.13097.
27. Grace R.F., Bianchi P., van Beers E.J., Eber S.W., Glader B., Yaish H.M., Despotovic J.M., Rothman J.A., Sharma M., McNaull M.M., Fermo E., Lezon-Geyda K., Morton D.H., Neufeld E.J., Chonat S., Kollmar N., Knoll C.M., Kuo K., Kwiatkowski J.L., Pospíšilová D., Pastore Y.D., Thompson A.A., Newburger P.E., Ravindranath Y., Wang W.C., Wlodarski M.W., Wang H., Holzhauer S., Breakey V.R., Kunz J., Sheth S., Rose M.J., Bradeen H.A., Neu N., Guo D., Al-Sayegh H., London W.B., Gallagher P.G., Zanella A., Barcellini W. Clinical spectrum of pyruvate kinase deficiency: data from the Pyruvate Kinase Deficiency Natural History Study. Blood 2018;131(20):2183–92. doi: 10.1182/blood-2017-10-810796.
28. Aksu T., Yarali N., Fermo E., Marcello A., Hacisalihoğlu Ş., Bianchi P., Özbek N.Y. A Case With Pyruvate Kinase Deficiency Remarkably Sensitive to Heat. J Pediatr Hematol Oncol 2018;40(7):e458–60. doi: 10.1097/MPH.0000000000001073.
29. Pereira J., Bento C., Manco L., Gonzalez A., Vagace J., Ribeiro M.L. Congenital dyserythropoietic anemia associated to a GATA1 mutation aggravated by pyruvate kinase deficiency. Ann Hematol 2016;95(9):1551–3. doi: 10.1007/s00277-016-2720-0.
30. Gallagher P.G., Glader B. Diagnosis of Pyruvate Kinase Deficiency. Pediatr Blood Cancer 2016;63(5):771–2. doi: 10.1002/pbc.25922.
31. Grace R.F., Rose C., Layton D.M., Galactéros F., Barcellini W., Morton D.H., van Beers E.J., Yaish H., Ravindranath Y., Kuo K.H.M., Sheth S., Kwiatkowski J.L., Barbier A.J., Bodie S., Silver B., Hua L., Kung C., Hawkins P., Jouvin M.H., Bowden C., Glader B. Safety and Efficacy of Mitapivat in Pyruvate Kinase Deficiency. N Engl J Med 2019;381(10):933–44. doi: 10.1056/NEJMoa1902678.
32. Olivier F., Wieckowska A., Piedboeuf B., Alvarez F. Cholestasis and Hepatic Failure in a Neonate: A Case Report of Severe Pyruvate Kinase Deficiency. Pediatrics 2015;136(5):e1366–8. doi: 10.1542/peds.2015-0834.
33. Shaikh H., Bakalov V., Shaikh S., Amjad A. Paravertebral Mass and Diff use Lymphadenopathy in a Patient with Pyruvate Kinase Deficiency: Malignancy or Alternative Etiology? Cureus 2019;11(6):e4849. doi: 10.7759/cureus.4849.
35. Zanella A., Fermo E., Bianchi P., Valentini G. Red cell pyruvate kinase deficiency: molecular and clinical aspects. Br J Haematol 2005;130(1):11–25. doi: 10.1111/j.1365-2141.2005.05527.x.
36. Zanella A., Bianchi P. Red cell pyruvate kinase deficiency: from genetics to clinical manifestations. Baillieres Best Pract Res Clin Haematol 2000;13(1):57–81. doi: 10.1053/beha.1999.0057.
37. Kedar P.S., Harigae H., Ito E., Muramatsu H., Kojima S., Okuno Y., Fujiwara T., Dongerdiye R., Warang P.P., Madkaikar M.R. Study of pathophysiology and molecular characterization of congenital anemia in India using targeted next-generation sequencing approach. Int J Hematol 2019;110(5):618–26. doi: 10.1007/s12185-019-02716-9.
Анемии возникающие в результате гемолиза
Патологический гемолиз может быть острым и хроническим. Протекать он может внутри сосудов и вне их, в основном, в селезенке и печени, которые в результате увеличиваются.
В случае внесосудистого гемолиза гемоглобин в макрофагах превращается в гемосидерин и железо утилизируется повторно. В случае внутрисосудистого - гемоглобин связывается с белком крови пентоглобином. Если последнего окажется недостаточно, гемоглобин, оставшийся свободным, фильтруется в клубочках, а канальцами почек реабсорбируется и железо также утилизируется вновь. Однако часть его теряется со слущивающимися клетками канальцевого эпителия. Если содержищие свободного гемоглобина в плазме достигает 250 мг/л, он выделяется с мочой и она приобретает очень темный, почти черный цвет. В результате гемоглобинурии теряется железо. Выраженный гемолиз приводит к образованию большого количества непрямого билирубина, поэтому может возникнуть желтуха.
В норме эритроциты живут 120 дней. Если продолжительность их жизни уменьшается, но не ниже 100-90 дней, гемолиз полностью компенсируется усилением эритропоэза. Он может возрасти в шесть- восемь раз. Более резкое сокращение длительности жизни эритроцитов ведет к анемии.
В зависимости от пр_ чин гемолиза анемии подразделяются на несколько подгрупп.
Гемолитические анемии вследствие генетических дефектов эритроцитов
Генетические дефекты эритроцитов, в результате которых может возникать гемолиз, разнообразны.
Аномалии гемоглобина
Аномалии гемоглобина встречаются в виде изменения соотношения нормальных его форм или в виде появления патологических.
Нормальные формы гемоглобина А,, А, и фетальный различаются составом полипептидных цепей (a-, b-, g-, d-цепи). Скорость синтеза каждой из них регулируется отдельным геном. Дефект его приводит к уменьшению синтеза той формы гемоглобина, в которую входит данная цепь. Цепи глобина, синтезирующиеся с нормальной скоростью и оставшиеся в избытке, денатурируются, осаждаются на клеточной мембране. Это приводит к ее ригидности и укорочению жизни эритроцитов.
Примером качественного нарушения структуры глобина может служить S-гемоглобиноз. Дефект заключается в нарушении в-цепей глобина из-за замещения одной молекулы глютамина валином. В ре-зультате изменяется заряд молекулы. В случае гомозиготности по патологичксому гену S-гемоглобин составляет до 100% всего гемоглобина. Такие эритроциты приобретают серповидную форму. В результате возникают агрегады, нарушающие микроциркуляцию вплоть до возникновения некрозов, а эритроциты разрушаются. Возникает тяжелая гемолитическая анемия. Большинство таких детей погибает в возрасте до трех лет. У лиц гетерозиготных содержание S-гемоглобина не превышает 15-40% и анемия может протекать субклинически. Однако образование серповидных клеток, а соответственно и резко выраженный гемолиз возникают у них в условиях ацидоза, например, при гипоксии.
Все формы наследственных аномалий гемоглобина объединяют понятием гемоглобинозы, Их описано более двухсот. Некоторые гемоглобинозы не проявляются клинически. Другие патологические формы гемоглобина обладают повышенным сродством к кислороду, что может вызвать гипоксию и привести к развитию эритроцитоза. Многие проявляются гемолитической анемией разной тяжести.
При некоторых гемоглобинозах эритроциты непригодны для развития в них малярийного плазмодия. Поэтому эти гены особенно распространены в тех регионах, где мощным фактором естественного отбора веками была тропическая малярия (“малярийный пояс” Земли). В частности это бывшие в прошлом малярийными районы Средней Азии и Закавказья.
Ферментные аномалии эритроцитов
Ферментные аномалии эритроцитов также могут быть причиной наследственной гемолитической анемии. Формы наследственной патологии, заключающиеся в дефекте каких-либо ферментов, называют энзимопении или энзимопатии. В эритроцитах чаще встречаются различные дефекты глюкозо-6-фофатдегилрогеназы. Наследуются они сцепленно с Х-хромосомой. Известно более 30 патологических аллелей (вариантов) этого гена, которые дают разную степень выраженности дефекта. Поэтому аномалии этого фермента не всегда проявляются спонтанным гемолизом. Анемия в одних семьях возникает в детском возрасте, в других - у подростков и даже у взрослых (болезни-генокопии). Реже встречаются другие энзимопении (дефицит пируваткиназы, гексокиназы, фосфофруктокиназы и др.). При энзимопениях, в случае отсутствия спонтанного гемолиза, он провоцируется веществами с прооксидантным действием.
При многих энзимопениях люди более устойчивы к тропической малярии. Поэтому эти формы наследственной патологии, как и гемоглобинозы, чаше встречаются среди коренного населения или выходцев из малярийных районов. Например, в некоторых районах Азербайджана лица с теми или иными дефектами эритроцитов составляют до 30% населения.
При аномалиях структуры мембран эритроцитов нарушается водно-солевой баланс клетки (снижается содержание калия и воды, а натрия часто возрастает). Эти формы наследственной патологии объединяют понятием цитопатии.
Такие эритроциты через несколько дней после выхода в кровоток приобретают сферическую форму - диаметр уменьшается, просветление в центре исчезает. Пластичность их снижается и, проходя селезенку; они фрагментируются и погибают.
При наличии различных генетических дефектов продолжительность жизни эритроцитов сокращается. Они гемолизируются вне сосудистого русла, в основном в селезенке. Она увеличивается. Возникает желтуха. Гемолиз может быть компенсирован усилением эритропоэза. Тогда количество эритроцитов и гемоглобина остается в пределах нормы и лишь на фоне специфического пойкилоцитоза обнаруживаются признаки ускорения эритропоэза - ретикулоцитоз, полихроматофилия, появляются ядерные предшественники эритроцитов, а также нередко шизоциты. При недостаточности регенераторных возможностей костного мозга количество эритроцитов снижается, формируется анемия.
Генетический дефект эритроцитов может быть приобретенным в результате соматической мутации клетки-родоначальницы эритропоэза. Тогда в крови наряду с нормальными эритроцитами появляются дефектные, неустойчивые к действию комплемента. Гемолиз происходит внутрисосудистый. На этой основе возникает болезнь Маркиафава-Микелли (пароксизмальная ночная гемоглобинурия).
Гемолитические анемии вследствие воздействия на эритроциты химических, механических и биологических факторов
Некоторые химические вещества, в зависимости от дозы, могут вызывать гемолиз у всех людей. Например, бензол, толуол и их нитропроизводные, свинец, мышьяк, сапонин, лецитин.
Вместе с тем, эритроциты некоторых людей повышенно чув-ствительны к действию химических веществ, особенно с проок- сидантным действием. Причиной этого часто является энзимопения, клинически спонтанным гемолизом не проявляющаяся (в частности, в случаях гетерозиготности). Отмечается индивидуальная непереносимость сульфаниламидов, салицилагов, некоторых противомалярийных препаратов, заменителей витамина К, фенилсемикарбазида, нитрофурантоина, фенотиазида, гипероксии, нитритов, нитратов, анилина и мн. др. Эритроциты плода и новорожденного менее стойки к действию этих веществ. Поэтому гемолиз может быть вызван появлением их в крови матери.
Гемолиз могут вызывать и эндогенные вещества, образующиеся, например, при повреждении почек.
Механическое повреждение эритроцитов возникает в случае острого или хронического ДВС, т.е. при тяжелых ожогах, сепсисе, обширных повреждениях тканей, при тяжелых инфекционных заболеваниях, при коллагенозах и др., когда в организме выделяется много простагландинов, которые изменяют мембрану эритроцитов и теряется их физиологическая способность деформироваться при прохождении по капиллярам и они повреждаются. Повреждаются они при ДВС также в связи с появлением в кровотоке нитей фибрина.
Механическому повреждению могут подвергаться эритроциты у отдельных лиц при длительной ходьбе, в связи с особенностями строения сосудов стопы. Могут повреждаться они при неудачном протезировании сердечных клапанов.
В случаях химического и механического повреждения эритроцитов гемолиз идет внутрисосудистый. Поэтому возможна гемоглобинурия и потеря железа.
Биологические факторы, способные вызвать гемолиз, это яд кобры, токсин гемолитического стрептококка, малярийный плазмодий, возбудители токсоплазмоза, инфекционного мононуклеоза и некоторые другие вирусы. Гемолиз в этих случаях может быть как внутри- так и внесосудистый.
Гемолитические анемии в результате иммунологических процессов
Аутоиммунные гемолитические анемии
Аутоиммунные гемолитические анемии возникают, когда против собственных неизмененных эритроцитов вырабатываются антитела. Это может быть в результате наследственных или приобретенных нарушений иммунологической системы, а именно дефекта Т-супрессоров, а также при доброкачественной или злокачественной гиперплазии лимфоидной ткани, например, при лимфолейкозах, лимфосаркоме, опухоли виолочковой железы. Гемолитические анемии возникают при многие аутоиммунных заболеваниях, таких как красная волчанка, ревматоидный полиартрит и другие коллагенозы. Аутоиммунная анемия может также возникнуть при инфекции в случае сходства антигенных детерминант возбудителя и эритроцитов человека.
Аутоантитела имеют различные свойства. Некоторые активизируются на холоду, а другие при повышении температуры. Поэтому гемолиз под действием аутоантител может протекать непрерывно или .возникать приступообразно. Например, так называемый гемолитический криз может возникнуть после охлаждения. Гемолиз в этих случаях, в основном, внутрисосудистый. Поэтому после гемолитического криза возникает гемоглобинурия.
Анемии в результате изменения антигенных детерминант эритроцитов
Антитела могут вырабатываться против своих эритроцитов при адсорбции на них вирусов, продуктов распада тканей, например, при опухолях, ожогах и др.
Многие лекарственные препараты могут адсорбироваться на эритроцитах или связываться белками плазмы. Против таких комплексов вырабатываются антитела. В первом случае реакция антиген- антитело на эритроцитах ведет к их гибели. Во втором - эритроциты страдают косвенно в результате иммунологической реакции антиген + антитело + комплемент. Сенсибилизирующим действием обладают, например, пенициллин, стрептомицин, цефалотин, изониазид, индометацин, фенилбутазон, фенацетин, дилантин, хлорпромазин и ряд других лекарств.
Иммунологический конфликт матери и плода
Если в кровь женщины при повреждении плаценты или во время родов попадут эритроциты плода, унаследовавшего от отца какой-либо антиген, которого нет у матери, то происходит продукция антител. Наибольшее значени. имеет несовместимость матери и плода по вариантам антигенов системы резус и системы АВО как наиболее распространенным. Иммунизация может также произойти, если резусотрицательной женщине (девочке) перелить резусположительную кровь. Опасность иммунизации матери резус-антигенами плода меньше, если имеется одновременно несовместимость крови еще и по системе АВО. В этом случае эритроциты плода, попав в организм матери, быстро выводятся из кровотока в результате действия на них естественных антител а и b и не успевают вызвать иммунологический ответ на резус-антиген. Несовместимость по резус-антигенам дает более тяжелые последствия, чем по системе АВО.
Антитела, выработавшиеся у матери, попадая в кровь плода, адсорбируются на эритроцитах, повреждая их. Такие клетки фагоцитируются макрофагами. Если гемолиз невелик, то плод может компенсировать его напряжением эритропоэза. Интенсивный гемолиз может привести к гибели плода или у новорожденного констатируется “гемолитическая болезнь”. В крови такого ребенка очень много ретикулоцитов (до 300%о и более), выражена полихроматофилия, много ядерных клеток красной крови, могут появляться мегалоциты. Увеличены печень и селезенка. Ярко выражена желтуха.
Характеристики гемолитических анемий
Группа гемолитических анемий наиболее разнообразная. По типу эритропоэза эти анемии нормобластические (за исключением гемо-литической болезни новорожденных). По интенсивности эритропоэза могут быть различны. В случаях острого гемолиза или в начале хроническою аиемия гиперрегенераторная, т.к. из эритроцитов при их разрушении выделяются эритропоэтины. В случаях продолжительного гемолиза, из-за истощения кроветворной ткани анемия может стать гипорегенераторной.
По насыщению эритроцитов гемог лобином чаще нормохромная. При гемолитической болезни новорожденного - гиперхромная. В случаях генетических дефектов (гемоглобинозы, энзимопатии) - нередко гипохромная.
В случае генетических дефектов эритроцитов часто появляется специфический пойкилоцитоз. т.е. анемия характеризуется дополнительно как сфероцитарная (“наследственный сфероцитоз”), серповидная, мишеневидная и т.п. Сфероцитоз и мишеневидность могут встречаться и при других анемиях.
Если гемолиз внутрисосудистый, в плазме возрастает содержание железа (гиперсидергмическая анемия).
При остром гемолизе, если одновременно не поражен костный мозг, характерным является нейтрофильный лейкоцитоз, а при аутоиммунных анемиях и связанных с протозойной или вирусной инфекцией, наоборот, лейкопения.
Принципы терапии
Лечение зависит от причины гемолиза и тяжести его. Например, если наследственный дефект эритроцитов приводит к нерезковыраженной анемии, лечение не проводится. Если же наследственная анемия очень тяжелая, периодически прибегают к переливанию эритроцитарной массы, но это усугубляет опасность гемосидероза. (Для удаления железа назначают десферал). При энзимопениях и цитопатиях, а также при аутоиммунных реакциях в случаях очень тяжелого течения болезни удаляют селезенку, чтобы продлить срок жизни эритроцитов. В случаях аутоиммунных анемий прибегают к подавлению иммунологической системы, в частности, путем введения глюкокортикоидов.
Необходимо устранить влияние экзогенных гемолизирующих факторов. Для профилактики гемолиза при лечении препаратами с прооксидантным действием рекомендуется назначать антиоксиданты, например, аскорбиновую кислоту. В случае острого гемолиза, представляющего опасность для жизни, прибегают к переливанию эритроцитарной массы (переливание цельной крови противопоказано из-за опасности усиления ДВС). Интенсивное лечение требуется в случаях гемолитической болезни новорожденных, если она резко выражена. Наибольшую опасность для ребенка представляет резкое повышение в крови непрямого билирубина, токсичного для клеток нервной системы. Он может вызвать необратимое ее повреждение. Для устранения билирубина и гипоксии прибегают к обменным переливаниям крови. Кровь
I группы, совпадающую с резус принадлежностью ребенка, вливают небольшими порциями (20-30 мл), предварительно выпустив
соответствующий объем крови ребенка. Но эта операция чревата многими осложнениями. Поэтому в нетяжелых случаях ограничиваются применением фенобарбитала, который активирует соединение билирубина с глюкуроновой кислотой, т.е. его дезинтоксикацию.
У доношенных детей анемия на почве резус-несовместимости выражена тяжелее, чем у рожденных на 2-3 недели раньше срока. Это связано с тем, что у недоношенных меньше резус-антигена на эритроцитах. Об интенсивности гемолиза можно судить по содержанию билирубина в околоплодных водах. В случае, если он резко выражен, прибегают к родоразрешению раньше срока. Антитела выделяются с молоком. Поэтому новорожденного около двух недель вскармливают молоком другой женщины.
В отличие от резус-конфликта при несовместимости по АВО не прибегают ни к обменным переливаниям, ни к досрочному родоразрешению, поскольку гемолитическая болезнь течет легче.
Дефицит пируваткиназы у плода. Гемоглобинозы
Медач | Medical Channel запись закреплена
1. Мембранопатии эритроцитов с характерной морфологией клеток (сфероцитоз, эллиптоцитоз, стоматоцитоз и др.).
2. Энзимопенические (ферментопенические) анемии, или эритроцитарные энзимопатии (связанные с дефицитом ферментов пентозо-фосфатного цикла - глюкозо-6-фосфатдегидрогеназы и др.; связанные с дефицитом ферментов гликолиза - пируваткиназы и др.; связанные с нарушением метаболизма нуклеотидов - дефицит пиримидин-5-нуклеотидазы и др.).
3. Гемоглобинопатии ("качественные" гемоглобинопатии - HbS, С, Д, Е и др. и "количественные" гемоглобинопатии - талассемии).
Мембранопатии. Основным патогенетическим звеном гемолитических анемий этой группы является генетический дефект белково-липидной структуры мембраны эритроцитов, что приводит к изменению формы и эластичности клеток. В результате нарушается способность эритроцитов деформироваться в узких участках кровотока, в частности при перехода из межсинусных пространств селезенки в синусы. В процессе циркуляции эритроциты постепенно теряют оболочку и в конечном счете разрушаются макрофагами селезенки. Из группы мембранопатий наиболее часто встречаемым заболеванием является наследственный микросфероцитоз (болезнь Минковского-Шоффара), в основе которого лежит наследственный дефект мембраны, способствующий повышенной проницаемости ее для ионов натрия. Проникновение в клетку избытка натрия, а вместе с ним и воды увеличивает объем эритроцитов и придает им характерную шаровидную форму. Удаляя избыток воды, сферические эритроциты постоянно тратят энергию, расходуя больше глюкозы и АТФ. Эти процессы наряду с механическим повреждением сфероцитов в синусоидах селезенки приводят к изнашиванию эритроцитов и сокращению срока их жизни до 14-12 дней. Аномалия передается с аутосомной хромосомой и наследуется по доминантному типу, т. е. болезнь проявляется и у гетерозигот.
Энзимопатии. Они обусловлены наследственным дефицитом ряда ферментов эритроцитов. В мире насчитывается несколько сотен миллионов человек (примерно 1/20 человечества) - носителей наследственного дефицита глюкозо-6-фосфатдегидрогеназы (Г-6-ФДГ). При недостатке Г-6-ФДГ блокируется реакция окисления глюкозо-6-фосфата в пентозо-фосфатном цикле, вследствие чего уменьшается образование восстановленной формы глютатиона, предохраняющего SH-группы глобина и мембраны эритроцитов от различного рода окислителей. Описано около 90 различных мутантных форм Г-6-ФДГ, 2 из которых являются основными: африканская форма дефицита - А и средиземноморская - В. Последняя характеризуется не только снижением активности Г-6-ФДГ, как это имеет место при африканской форме, но и уменьшением количества ее в эритроцитах. Дефицит Г-6-ФДГ наследуется как сцепленный с Х-хромосомой признак, поэтому среди заболевших лиц преобладают мужчины. Клинические проявления носительства Г-6-ФДГ, развивающиеся по типу острого гемолитического криза, наблюдаются при приеме некоторых лекарств, обладающих окислительными свойствами: хинин, ПАСК, сульфаниламиды, производные салициловой кислоты и др., употреблении в пищу конских бобов и стручковых растений (фавизм), а также на фоне заболевания вирусным гепатитом или гриппом.
Гемоглобинопатии (гемоглобинозы). Данные заболевания связаны с наследственным нарушением синтеза гемоглобина. "Качественные" гемоглобинопатии сопровождаются нарушением первичной структуры гемоглобина, "количественные" гемоглобинопатии характеризуются снижением скорости синтеза полипептидных цепей глобина. Как и носительство дефицита Г-6-ФДГ, наследственные гемоглобинопатии относятся к числу наиболее распространенных в человеческой популяции генетических аномалий. Среди известных форм гемоглобинопатии наибольшее значение в практическом отношении представляют гемоглобиноз S (серповидно-клеточная анемия) и талассемия.
Гемоглобиноз S. Заболевание возникает в связи с наследованием патологического гемоглобина S, в котором гидрофильная глутаминовая кислота в 6-м положении бета-цепи глобина замещена на гидрофобный валин. Такая замена изменяет суммарный заряд молекулы гемоглобина, уменьшает его растворимость. При падении парциального давления кислорода происходит агрегация (кристаллизация) гемоглобина, что и лежит в основе одного из важнейших признаков гемоглобиноза S - серповидности эритроцитов. Серповидные эритроциты (или дрепаноциты) повышают вязкость крови, замедляют кровоток, вызывают стаз. Стаз, в свою очередь, приводит к развитию гипоксемии, еще более увеличивая образование серповидно-клеточных эритроцитов. В результате уменьшается прочность мембран дрепаноцитов, увеличивается их гемолиз. Тяжелая анемия проявляется лишь у гомозиготных по HbS носителей.
Талассемия (средиземноморская анемия). Она связана с нарушением скорости синтеза альфа-, бета- или гамма-цепи нормального гемоглобина A1 и в зависимости от этого различают альфа-, бета- и гамма-талассемию. Чаще всего встречается нарушение скорости синтеза бета-цепей. В этом случае содержание Hb A1 (с цепями альфа2бета2) уменьшается, а уровень Hb F(альфа2гамма2) и Hb A2 (альфа2сигма2), напротив, возрастает (у здорового человека НЬ А1 составляет 95-98%, Hb A2 - 2-2,5%, Hb F - 1-2%). Недостаточный синтез бета-цепей приводит к избыточному образованию альфа-цепей. Лишние альфа-цепи способствуют появлению нестабильного гемоглобина, который преципитирует и выпадает в эритроците в виде "телец включения", придавая им форму мишеней. Кроме того, образующиеся в избытке альфа-цепи вступают в соединения с SH-группами мембраны и повышают ее проницаемость. Все это ведет к повышенному гемолизу. Развернутая картина тяжелой гемолитической анемии возникает при гомозиготном наследовании нарушения синтеза бета-цепей (болезнь Кули).
Приобретенные гемолитические анемии.
Среди заболеваний этой группы выделяют иммунные гемолитические анемии и анемии, связанные с воздействием прямых гемолизинов и других повреждающих факторов.
1) Иммунные гемолитические анемии. Данные анемии характеризуются образованием антител, действие которых направлено против антигенов, находящихся на поверхности эритроцитов.
а) Аутоиммунные гемолитические анемии (АИГА). Они возникают в результате образования антител к собственным эритроцитам. Выработка антиэритроцитарных аутоантител может быть связана с изменением антигенной структуры мембраны эритроцитов в результате воздействия различных повреждающих факторов либо обусловлена нарушениями в самой иммунокомпетентной системе больного. В основе патологического процесса большинства форм АИГА лежит срыв иммунологической толерантности к собственному антигену. Считается, что это возникает лишь в тех случаях, когда она связана с воздействием малых доз толерогена и с нарушенной функцией Т-клеток при нормальном функционировании В-лимфоцитов. Антиэритроцитарные аутоантитела могут уничтожающе действовать на эритроциты крови, эритронормобласты костного мозга и даже на самые ранние клетки - предшественники эритроцитов периферической крови. По серологическому типу выделяют АИГА с неполными тепловыми агглютининами (IgG, реже IgM и IgA), с тепловыми гемолизинами, с холодовыми агглютининами (IgM, реже IgG) и двухфазными агглютининами (IgG). АИГА, вызываемые тепловыми аутоантителами, развиваются либо без видимых причин (идиопатическая форма), либо на фоне различных заболеваний - лимфогранулематоза, хронического лимфолейкоза, системной волчанки (симптоматическая форма), а также при приеме некоторых лекарств (пенициллин). Действие холодовых аутоантител проявляется при температуре ниже 32° С. Агглютинация и последующее разрушение эритроцитов происходят главным образом в мелких сосудах отдаленных от сердца участков тела (пальцы, уши) при охлаждении. Двухфазные гемолизины при охлаждении организма оседают на поверхности эритроцитов, а гемолиз вызывают при 37° С.
б) Изоиммунные гемолитические анемии. Заболевания возникают при воздействии изоиммунных антител. К этой группе анемий относят гемолитические анемии, связанные с резус-несовместимостью или несовместимостью по группе АВО между матерью и плодом. Сюда же относятся и посттрансфузионные анемии, обусловленные несовместимостью по групповой или резус-принадлежности.
Гемолитическая болезнь (эритробластоз) новорожденных. Она может возникнуть при беременности резус-отрицательной матери резус-положительным плодом, когда в организме матери начинают вырабатываться антитела, вызывающие агглютинацию эритроцитов плода. Особую опасность в этом отношении представляют повторные беременности, когда в крови матери уже есть антитела после предшествовавших беременностей.
2) Анемии при действии прямых гемолизинов и других повреждающих факторов. Эта группа анемий объединяет гемолитические состояния, при которых полноценные в морфофункциональном отношении эритроциты разрушаются под действием гемолитических (фенилгидразий, свинец, бензол, мышьяковистый водород, анилиновые красители, змеиный и грибной яды и др.), бактериальных (токсины гемолитического стрептококка, стафилококка и др.), паразитарных (малярия) и других факторов. Патогенез этих анемий различен: разрушение мембраны эритроцитов, истощение их ферментных систем и т. д.
Читайте также:
